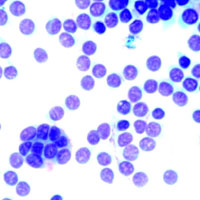
Когда нападают зомби: пять паразитов, кошечки и неизбежный апокалипсис

Наталья Резник
«Троицкий вариант» №20(164), 7 октября 2014 года
Птицы по-разному относятся к своему потомству. Одни виды о нем заботятся, другие норовят переложить эту обязанность на других и откладывают яйца в чужие гнезда. Это явление получило название гнездового паразитизма. Птенцы паразита объедают птенцов хозяина и, если размеры позволяют, выталкивают их из гнезда. Хозяева гнезд по мере сил защищаются, выкидывая подложенные яйца, а также отгоняя и преследуя взрослых птиц. Однако паразитов гоняют не все, и биологи предположили, что хозяева извлекают из присутствия чужих птенцов какую-нибудь выгоду.
В 1968 году сотрудник Смитсониановского института исследования тропиков (Smithsonian Tropical Research Institute) Нил Смит (Neal Smith) наблюдал в Панаме за большой воловьей птицей Scaphidura oryzivor — гнездовым паразитом, который подкладывает свои яйца птицам семейства тупиаловых, в том числе желтопоясничному черному кассику Cacicus cela и оропендоле Zarhynchus wagleri. У разных самок S. oryzivor яйца выглядят по-разному, иногда они очень похожи на хозяйские, в других же случаях отличаются настолько, что обнаружить их не составляет труда. Казалось бы, их тут же должны выбросить, некоторые хозяева так и поступают, другие же равнодушно смотрят, как S. oryzivora откладывает свои яйца в их гнездо, и потом никаких мер не принимают. Но их снисходительность окупается: птенцы большой воловьей птицы вылупляются первыми и вскоре уже склевывают разных насекомых, ползающих в гнезде, в том числе личинок оводов Philornis sp., которые вбуравливаются под кожу нежным хозяйским птенчикам и могут даже заесть их до смерти. Птенцы S. oryzivora покрыты плотным пухом, и им эти личинки не страшны. Таким образом, большая воловья птица выступает в двух ипостасях: гнездового паразита и защитника хозяйских детей (при умеренном уровне паразитизма, разумеется). Впрочем, тупиаловые птицы могут обойтись и без защиты подброшенных птенцов. Те из них, кто предпочитает избавляться от чужих яиц, устраивают гнезда рядом с лесными осами Protopolybia sp. и Stelopolybia sp. или пчелами Trigona sp. (у них мощные челюсти). Эти насекомые охотятся на оводов и прекрасно защищают птенчиков.
Описывая этот случай, Нил Смит отметил, что взаимодействие гнездовых паразитов и хозяина не всегда таково, каким кажется на первый взгляд. Его работа приобрела широкую известность, даже вошла в учебники, однако вывод не получил подтверждения, и до сих пор птицы, откладывающие яйца в чужие гнезда, считались чистейшей воды паразитами. Недавно к этому вопросу вернулись испанские исследователи под руководством Витторио Баглионе (Vittorio Baglione), профессора Университета Вальядолида (University of Valladolid), и Даниелы Канестрари (Daniela Canestrari) из Университета Овьедо (University of Oviedo). Они обнаружили, что некоторые птицы действительно получают выгоды от чужих птенцов в своем гнезде.
На сей раз объектом исследования стала хохлатая кукушка Clamator glandarius, обитатель Юго-Западной и Южной Европы и Малой Азии. Она специализируется на гнездах врановых, в основном сороки Pica pica и черной вороны Corvus corone corone. Сороки по мере сил борются с паразитами, а кукушки заметно снижают численность их потомства. Однако вороны от кукушек видимым образом не страдают, хотя более 67% вороньих гнезд заражены яйцами C. glandarius, и вороны их не выкидывают.
Ученых заинтересовало, получают ли вороны какое-то преимущество от присутствия кукушат в своем гнезде. Они проанализировали данные, собранные в течение 16 лет наблюдений, и оценили влияние паразитов на репродуктивный успех ворон. Оказалось, что яйца во всех вороньих гнездах, независимо от того, заражены ли они, проклевываются примерно с одинаковой вероятностью (0,77–0,73). Кладку, в которой хотя бы один хозяйский птенец дожил до оперения, считают успешной. Среди проклюнувшихся зараженных кладок вероятность успеха была немного выше (0,764 и 0,538 соответственно). Однако в успешных зараженных выводках воронят меньше. Так что в итоге присутствие кукушек хоть и дает воронам преимущество, но небольшое.
Усредненные многолетние данные не прояснили ситуацию, и тогда исследователи перешли от наблюдений к активным действиям. Они забирали кукушат из «родных» гнезд и перемещали в другие, изначально не зараженные. Таким образом, в эксперименте участвовало четыре группы гнезд: зараженные, незараженные, зараженные с изъятым кукушонком и незараженные, в которые подложили чужого птенца (см. рисунок). Тут и проявилась связь между гнездовым паразитизмом и успехом кладки. Вероятность успеха в обычной зараженной (контрольной) кладке составляет около 0,7. Если удалить из нее кукушат (обычно их 1–2 в гнезде), вероятность успеха снизится до 0,3, а если подложить кукушкины яйца к незараженной вороней кладке, вероятность успеха возрастет вдвое, с 0,37 до 0,71. В контрольных экспериментах из кладок удаляли воронят, но эти действия не повлияли на их успешность.

Присутствие кукушат в гнезде защищает хозяйских птенцов от хищников (Canestrari et al., 2014)
Причина успеха заключается в зловонном секрете, который схваченный кукушонок выделяет из клоаки. Объем секрета значительный, около миллилитра, в его состав входят едкие и дурно пахнущие вещества: кислоты, индолы, фенолы. Они отпугивают хищников, посягающих на беззащитных птенцов, в том числе диких кошек Felis silvestris, генетт Genetta genetta, каменных куниц Martes foina, ястребов-тетеревятников Accipiter gentilis и сарычей Buteo buteo, воронов Corvus corax и соек Garrulus glandarius.
Испанские ученые проверили действие пахучего секрета на трех главных группах хищников, угрожающих вороньим яйцам: одичавших кошках, врановых и хищных птицах. Им предлагали куски курицы, смоченные водой или обработанные секретом кукушат. Кошки не отказывались от мокрой курицы, но лишь одна из десяти попробовала кусок, пропахший кукушонком. Птицы также избегают этого аромата.
Нападению хищников подвергается не меньше половины вороньих гнезд, поэтому кукушки приносят им существенную пользу. Степень их полезности зависит от численности хищников; таким образом, взаимоотношения хохлатой кукушки и черной вороны могут колебаться от паразитизма до комменсализма (взаимовыгодного сотрудничества). Впрочем, ущерб, который паразиты наносят хозяевам, не так уж и велик. Когда кукушка откладывает свои яйца, она никогда не портит яйца вороны. Кукушонок весит примерно в три раза меньше птенца вороны, так что выкормить его легче, чем родное дитя. Вес и состояние воронят, выросших вместе с кукушатами, не хуже, чем у птенцов, которые росли без паразитов.
Так что межвидовые взаимодействия не всегда можно классифицировать однозначно, и, если вы застали кукушку за откладыванием яиц в чужое гнездо, это, возможно, совсем не то, что вы подумали.
1. N. Smith (1968), The Advantage of being Parasitized. Nature 219: 690–694. DOI:10.1038/219690a0.
2. D. Canestrari et al., (2014), From Parasitism to Mutualism: Unexpected Interactions Between a Cuckoo and Its Host. Science 343: 1350–1352. DOI:10.1126/science.1249008.